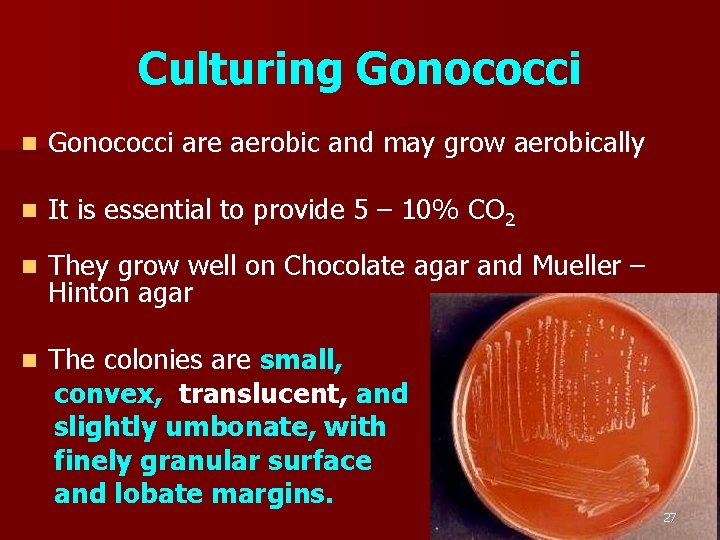
Culturing Gonococci n Gonococci are aerobic and may grow aerobically n It is essential
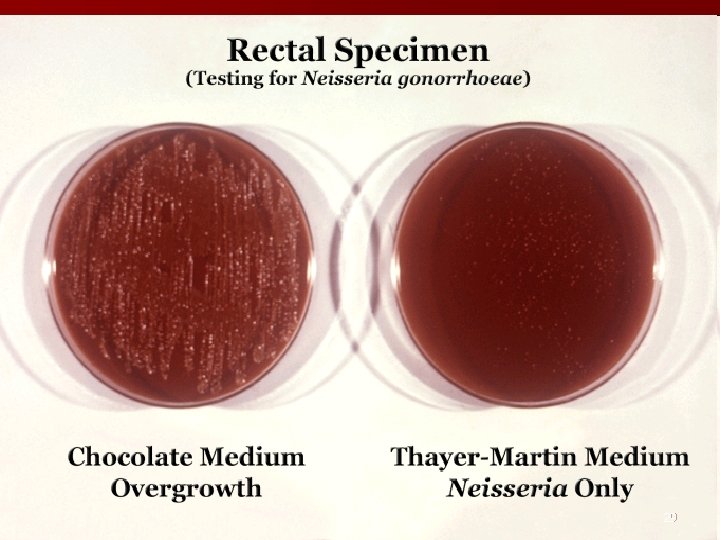
29
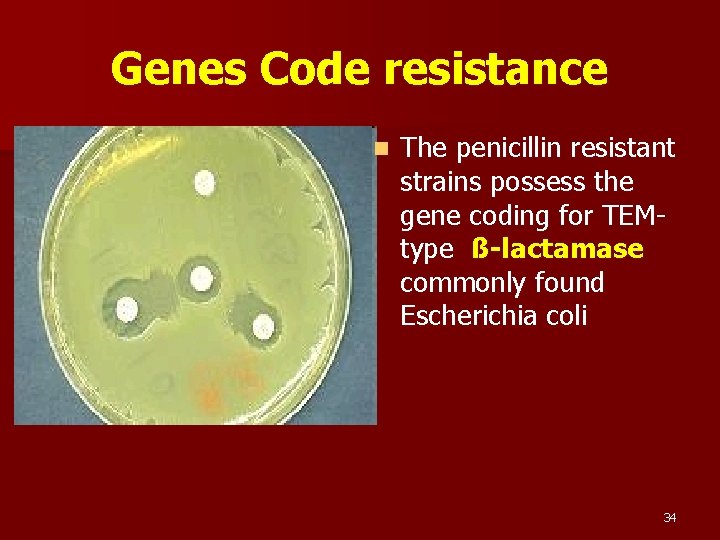
Genes Code resistance n The penicillin resistant strains possess the gene coding for TEMtype

NEISSERIA GONORRHOEAE Albert Ludwig Sigesmund Neisser was a

NEISSERIA GONORRHOEAE

Albert Ludwig Sigesmund Neisser was a German physician who specialized in dermatology and venereal diseases. n He discovered gonococcus (1879), the small bacterium that causes gonorrhoea. n 2

Gonorrhea n The name Gonorrhea is derived from Greek words- Gonos ( seed ) rhoia ( flow ) n Describes a condition in which semen flowed from the male organ without erection, 3

Gonorrhea – Venereal Disease n Gonorrhea is a classical venereal disease, being spread almost exclusively by sexaul contact having a short incubation period and being relatively easy to diagnose and treat. 4

Neisseria gonorrhea n Neisseria gonorrhea are gram negative oval cocci with opposing surfaces slightly concave ( Bean shaped ) 5

Neisseria gonorrhea n Neisseria species are Gram-negative cocci, 0. 6 to 1. 0 µm in diameter. n The organisms are usually seen in pairs with the adjacent sides flattened. n Pili, hairlike filamentous appendages extend several micrometers from the cell surface. n The outer membrane is composed of proteins, phospholipids, and Lipopolysacchride (LPS) 6

N. gonnorhea infects mucous membrane n Gram-negative intracellular diplococci of the species Neisseria gonorrhoea, the cause of gonorrhoea; n a nonmotile aerobic microorganism of the species N. gonorrhoea. n It is a parasite of the mucous membrane. 7

Pathogenesis n N. gonnorhea is Human pathogen. n Chimpanges can be infected artificially n Women may remain Asymptomatic n Gonorrhea infection is generally limited to superficial mucosal surfaces lined by columnar epithelium. 8

PATHOGENESIS 9

The Organs and Tissues involved n n n n Cervix Urethra Rectum Pharynx Conjunctiva Vaginal epithelium – covered with Squamous epithelium not infected However prepubertal vaginal epithelium is infected in young girls present with vulvovaginitis 10

CLINICAL MANIFESTATIONS 11

Pathogenesis ( contd ) n n n Gonorrhea is Venereal disease The disease is acquired by sexaul contact. In general incubation is 2 -8 days In men the disease starts as purulent discharge containing gonococci in large numbers. The disease spreads to prostate, seminal vesicle, and epididymis In men chronic urethritis may lead to stricture formation 12

Clinical Presentation in Males n Majority of males present with acute Urethritis with purulent discharge n 5% of patients carry bacteria without distress n Rectal and Pharyngeal infections are less often symptomatic 13

Clinical Presentation in Females n Endocervix infection is the most common presentation in women n Present with vaginal discharge and Dysuria n Infection and abscess of Bartholin and Skene’s glands 14

Complications of GC Infections in Women Upper Tract Infection Genital Infection § Infertility § Ectopic Pregnancy § Chronic Pelvic Pain § Psychosocial Local Invasion Systemic Infection Congenital Infection HIV Infection 15

Other Manifestations n Rectal infection (Proctitis) with N. gonnorhea occurs n n one third of women with cervical infection. Rarely symptomatic. Acute salphingits Pelvic inflammatory disease Sterility 16

Other Manifestations n Peritonitis can spread n Fitz Hugh Curtis Syndrome. n Disseminated gonococcus infection n Painful Joints may lead to Arthritis n Fever, Few septic lesions on the extremities n Meingitis and Endocarditis 17

Gonococcal Opthalmia n Babies born to infected women suffer, can lead to a serious condition of Opthalmia neonatroum n Manifest with sever purulent discharge with periorbital edema within a few days of birth n Topical application of 1% silver nitrate has drastically reduced the incidence. n In present contest Topical erythromycin is used. 18

Gonococcal infection in Prepubertal Girls n Vulvo-vaginitis in prepubertal girls occur in conditions of poor hygiene or by sexual abuse n All cases to be investigated with care and caution. 19

Disseminated Infections n Seen more commonly in women who may present with painful joints, fever, and few septic lesions or the extremities n Rarely disseminated infections may present as Endocarditis or meningitis. 20

Laboratory Diagnosis n Specimens are collected with care and caution. n Specimens are collected from sites with scanty commensals eg Endocervix 21

Transportation of Specimens n It is preferred in culture, specimens should be inoculated in prewarmed plates, immediately on collection n If not possible specimen should be collected on charcoal impregnated swabs and sent to laboratory in Stuart’s transport medium. 22

GC Diagnostic Methods n Gram stain smear n Culture n Antigen Detection Tests: EIA & DFA n Nucleic Acid Detection Tests – Probe Hybridization – Nucleic Acid Amplification Tests (NAATs) – Hybrid Capture 23

Gonorrhea Diagnostic Tests Sensitivity Specificity Gram stain 90 -95% >95% (male urethra exudate) DNA probe Culture 85 -90% 80 -95% NAATs * 90 -95% >99% 98% * Able to use URINE specimens 24

Gram Staining Gram’s method of staining is sensitive in 95% of infections. n The demonstration of intracellular Gram negative intracellular diplococci in stained smears provides a presumptive evidence of gonorrhea in men. n Specimens are inoculated onto culture plates freshly prepared. n Delay in inoculation of specimens on culture media reduces the rate of isolation. n 25

GC Culture Candle Jar 26
Culturing Gonococci n Gonococci are aerobic and may grow aerobically n It is essential to provide 5 – 10% CO 2 n They grow well on Chocolate agar and Mueller – Hinton agar n The colonies are small, convex, translucent, and slightly umbonate, with finely granular surface and lobate margins. 27

Selective Culture Medium n The selective medium is Thayer – Martin medium containing Vancomycin, colistin, and Nystatin, effectively inhibits most contaminants including non pathogenic Neisseria 28
29

Culturing is possible in specialized diagnostic laboratories only. n n The combination of Oxidase positive colonies and Gram negative diplococci provides a presumptive diagnosis. 30

Fluorescent Methods n Florescent methods will help in prompt detection in infected patients n Various discharges can be examined. 31

Other Methods in Diagnosis n Co agglutination methods n Biochemical tests to differentiate from other commensals resembling Neisseria spp 32

Treatment Penicillin was a popularly used antibiotic. However resistance has reduced it utility. n n For a long time the drug resistance has overcome with increased dosage n Complete resistance to penicillin has made the drug obsolete in several parts of the world. 33
Genes Code resistance n The penicillin resistant strains possess the gene coding for TEMtype ß-lactamase commonly found Escherichia coli 34

Other Drugs in current use Ceftriaxone Cefixime Fluoroquinolones Ciprofloxacin Tetracycline Co- Amoxiclav Spectinomycin In Disseminated Gonococcal disease and any complicated infection treatment for 710 days is necessary n n n n 35

Controlling Gonorrhea n The key control measures in gonorrhea are 1 Rapid diagnosis 2 Use of effective antibiotics 3 Tracing, examination and treatment of contacts. 4 Inappropriate self medication has contributed to widespread antimicrobial resistance. 36

NON-GONOCOCCAL URETHRITIS n Chronic urethritis where gonococci cannot be demonstrated. n Can be considered as non-specific urethritis. Urethritis forms part of the syndrome consisting of conjunctivitis and arthritis (Reiter's syndrome). n n May be also due to Gonococcal infection, the cocci persisting as l-forms and hence undetectable by routine tests. n 37

CAUSATIVE AGENTS: n n n n Chlamydia trachomatis Ureaplasma urelyticum. Mycoplasma hominis. Herpes virus Cytomegalo virus. Trichomonas vaginalis. Candida albicans. Can also be due to mechanical or chemical irritation. n Management: difficult. n 38
- Slides: 38